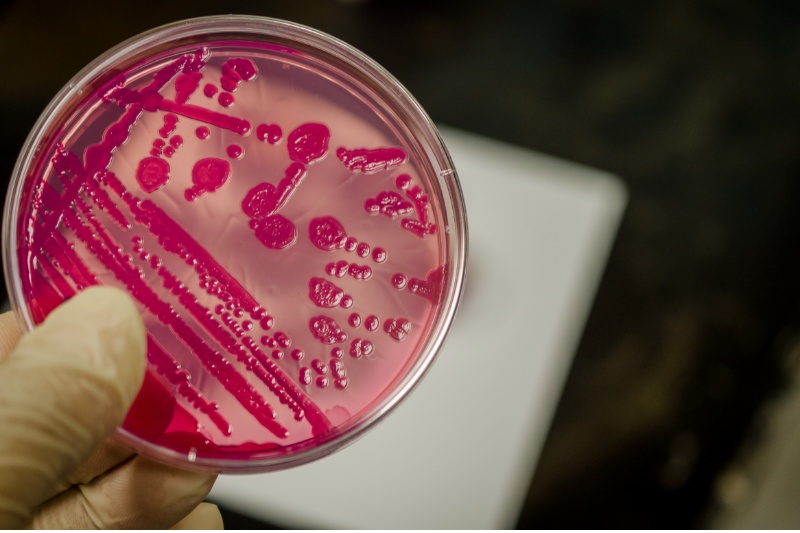

Bệnh lậu giai đoạn đầu là một một bệnh thuộc nhóm bệnh lây truyền qua quan hệ tình dục, phổ biến ở cả nam và nữ, đặc biệt là trong độ tuổi thanh thiếu niên. Ở giai đoạn đầu, căn bệnh này có khả năng lây lan cao nên rất ít người đề phòng song không phải ai cũng biết cách phát hiện cũng như phòng ngừa bệnh hiệu quả. Cùng Docosan tìm hiểu bệnh lý này trong bài viết dưới đây.
Tóm tắt nội dung
Xét nghiệm chẩn đoán bệnh lậu giai đoạn đầu tại nhà cùng Docosan
Bệnh lậu giai đoạn đầu thường khó phát hiện bởi những triệu chứng đối khi bị nhầm lẫn với các bệnh lý khác. Mặt khác, bạn không thể nhận biết bản thân mình có đang bị nhiễm bệnh lậu hay không nếu chỉ dựa vào triệu chứng lâm sàng. Chuyên gia y tế khuyến nghị những đối tượng có nguy cơ hay nghi ngờ bản thân bị nhiễm bệnh lậu cần chủ động xét nghiệm sớm, từ đó có phương pháp điều trị phù hợp cũng như phòng ngừa bệnh chuyển sang giai đoạn nặng hơn.
Thay vì kiểm tra tại phòng khám, bạn có thể lựa chọn dịch vụ chẩn đoán bệnh lậu giai đoạn đầu tại nhà của Docosan với gói Xét nghiệm các bệnh xã hội (STD) phổ biến. Ngoài chẩn đoán bệnh lậu, gói xét nghiệm này còn chuẩn đoán các bệnh lây qua đường tình dục khác như: HIV, giang mai và Chlamydia. Vì thực hiện tại nhà nên bạn có thể phần nào an tâm, riêng tư, tiện lợi và không lo sợ bị người khác phán xét khi có kết quả.

Sau khi có kết quả, bạn sẽ được hỗ trợ kết nối với bác sĩ chuyên khoa để hướng dẫn đọc kết quả, giải thích và tư vấn phương pháp điều trị bệnh phù hợp. Bên cạnh đó, bác sĩ còn tư vấn thêm phương pháp phòng ngừa lây bệnh.
Mời bạn tham khảo sản phẩm Bộ Xét Nghiệm Các Bệnh Xã Hội (STD) Phổ Biến
Tổng quan về bệnh lậu giai đoạn đầu
Bệnh lậu là một trong những bệnh lý lây truyền chủ yếu nhất qua đường quan hệ tình dục không an toàn phổ biến. Căn bệnh này phổ biến ở cả nam và nữ, trong đó nhóm đối tượng có khả năng mắc bệnh cao là vị thành niên. Bệnh lậu là một bệnh nhiễm trùng, có nguyên nhân là vi khuẩn lậu (Neisseria gonorrhoeae), một song cầu khuẩn gram âm.

Khả năng lây truyền bệnh lậu rất cao, cũng như những biến chứng của bệnh vô cùng nguy hiểm. Cầu khuẩn lậu có thể gây nhiễm trùng ở nhiều cơ quan khác nhau trên cơ thể người bệnh, phổ biến nhất là bộ phận sinh dục rồi đến trực tràng, cổ họng… Vì thế việc nhận biết những biểu hiện của bệnh lậu giai đoạn đầu là vô cùng quan trọng trong việc chẩn đoán và điều trị bệnh từ sớm.
Triệu chứng của bệnh lâu giai đoạn đầu
Bệnh lậu có thể xuất hiện ở cả nam lẫn nữ không phân biệt lứa tuổi, và có thể dễ dàng bị nhiễm bệnh khi quan hệ tình dục không an toàn với người đã bị nhiễm bệnh lậu. Tương tự HIV, bệnh lậu cũng có khả năng lây từ mẹ sang con trong giai đoạn mang thai cũng như qua đường máu. Triệu chứng của bệnh lậu không giống nhau ở 2 giới nam và nữ, ngoài ra nó còn phụ thuộc vào thể trạng của người bệnh.
Triệu chứng của bệnh lậu giai đoạn đầu ở nữ giới
Bệnh lậu ở nữ thường tiến triển thầm lặng từ từ và không hề có triệu chứng nổi bật ở giai đoạn đầu. Nếu có, chúng thường gây nhẫm lẫn với các bệnh lý viêm nhiễm phụ khoa thường gặp. Chính vì vậy nhiều chị em đã chủ quan không để ý đến các biểu hiện của bệnh lậu giai đoạn đầu, khiến cho việc điều trị rất khó khăn, cũng như bệnh dễ tiến triển nặng, ảnh hưởng nhiều đến sức khỏe.

Những biểu hiện của bệnh lậu giai đoạn đầu ở nữ giới bao gồm:
- Tiểu nhiều, tiểu gắt buốt hoặc tiểu đau.
- Khi quan hệ tình dục bị đau bụng, chủ yếu ở vùng bụng dưới.
- Dịch tiết âm đạo lượng nhiều bất thường, có mùi hôi khó chịu. Màu sắc của dịch tiết có thể vàng xanh hoặc vàng đục. Khi thăm khám cổ tử cung sẽ thấy sưng tấy, phù nề. Nếu ấn vào có thể chảy máu và dịch mủ.
- Niệu đạo viêm đỏ, có mủ hoặc dịch đục.
- Đau bụng dưới, đau lưng, xuất huyết âm đạo ngoài chu kỳ kinh.
- Ngoài ra bệnh lậu giai đoạn đầu ở nữ giới còn có thể có ngứa hậu môn, xuất huyết và đau rát khi đại tiện.
Triệu chứng bệnh lậu giai đoạn đầu ở nam giới
Khác với nữ giới, triệu chứng bệnh lậu giai đoạn đầu ở nam giới sẽ khởi phát sớm kể từ sau khi nhiễm cầu khuẩn lậu khoảng 2 ngày, các trường hợp khác có thể trễ hơn. Triệu chứng ở nam giới vừa khởi phát sớm vừa biểu hiện nổi bật. Tuy nhiên vẫn có những trường hợp nam giới không biểu hiện bất kì triệu chứng nào rõ ràng nhưng vẫn có thể lây lan bệnh lậu cho người khác. Các bệnh lý mà vi khuẩn lậu gây ra ở nam giới bao gồm:
Viêm niệu đạo
Viêm niệu đạo do lậu là biểu hiện bệnh lậu giai đoạn đầu phổ biến nhất ở nam giới với các biểu hiện như sau:
- Viêm, sưng đỏ miệng lỗ sáo
- Tiểu mủ, tiểu buốt, lượng mủ nhiều, mủ có màu xanh hoặc vàng đục
- Tiểu rắt, tiểu khó, thậm chí có thể tiểu ra máu ở cuối dòng
Những triệu chứng trên ngày một nghiêm trọng hơn nếu không được phát hiện từ sớm.

Nhiễm trùng hậu môn trực tràng
Tình trạng này phổ biến hơn ở những đối tượng quan hệ đồng giới nam với các triệu chứng như:
- Hậu môn ngứa
- Có dịch mủ nhầy tiết ra từ hậu môn nhưng không đau, soi hậu môn thấy niêm mạc phù nề, sưng đỏ
- Đôi khi có hiện tượng xuất huyết trực tràng
Viêm nhiễm hầu họng
Viêm nhiễm hầu họng là tình trạng phổ biến ở những đối tượng quan hệ đồng giới nam hoặc oral sex (quan hệ tình dục bằng miệng), bệnh được biểu hiện như sau:
- Viêm amygdale cấp tính
- Viêm họng cấp, họng sưng đỏ, đau rát
- Hạch cổ sưng to
- Miệng nổi các nốt giống nhiệt miệng
- Có thể kèm sốt hoặc không
Biểu hiện trên các cơ quan khác
Bệnh lậu cũng là nguyên nhân gây nhiễm trùng nhiều cơ quan khác mặc dù hiếm gặp hơn. Điển hình như viêm kết mạc mắt, nhiễm trùng da ở bộ phận sinh dục, đùi, ngón tay, mông,…
Biểu hiện bệnh lậu ở trẻ sơ sinh
Trẻ sơ sinh thường bị lây bệnh lậu từ người mẹ của mình trong quá trình mang thai. Ngoài ra, quá trình sinh thường qua ngả âm đạo cũng có thể khiến trẻ mắc bệnh nếu người mẹ cũng đang nhiễm vi khuẩn lậu.

Bệnh lậu giai đoạn đầu ở trẻ sơ sinh có thể khởi phát sớm chỉ khoảng sau 2 ngày kể từ khi chào đời. Triệu chứng phổ biến gồm phù nề, sưng đỏ mắt, chảy dịch mủ vàng từ mắt, viêm đỏ và loét giác mạc. Nếu trẻ không được phát hiện và điều trị kịp thời có thể dẫn đến những biến chứng nghiêm trọng, thậm chí gây mất thị lực vĩnh viễn (mù).
Biến chứng của bệnh lậu
Bệnh lậu giai đoạn đầu nếu không được điều trị kịp thời và đúng phác đồ sẽ có thể dẫn đến những biến chứng nghiêm trọng.
Đối với nam giới
- Viêm đường tiết niệu: viêm hẹp niệu đạo, viêm tuyến tiền liệt và viêm bàng quang.
- Viêm tinh hoàn, túi tinh, thậm chí có thể dẫn đến teo tinh hoàn,… ảnh hưởng nghiêm trọng đến hoạt động tình dục và cả khả năng sinh sản của nam giới.
- Tình trạng nguy hiểm nhất là ung thư tinh hoàn.

Đối với nữ giới
Nữ giới có khả năng đối mặt với một số biến chứng của bệnh lậu nếu không được phát hiện sớm và điều trị đúng phương pháp:
- Bệnh lậu giai đoạn đầu ở nữ nếu không được điều trị kịp thời sẽ dẫn đến các bệnh lý phụ khoa nguy hiểm, điển hình như viêm tử cung, viêm âm đạo, viêm vòi và buồng trứng.
- Tình trạng viêm nhiễm về phụ khoa gây đau rát khi nữ giới quan hệ tình dục, từ đó ảnh hưởng nghiêm trọng đến đời sống vợ chồng của bệnh nhân.
- Ngoài ra, bệnh lậu có thể gây ra các biến chứng nguy hiểm bao gồm vô sinh, sảy thai, thai ngoài tử cung, sinh non, dị tật bẩm sinh thai nhi,…
- Bệnh lậu giai đoạn đầu cũng gây ảnh hưởng tâm lý của người bệnh, gây tâm lý tự ti về tình trạng bệnh của mình.
Các xét nghiệm chẩn đoán bệnh lậu giai đoạn đầu
Nếu nhận thấy bản thân hoặc vợ/chồng hoặc bạn tình của bạn có những triệu chứng của bệnh lậu giai đoạn đầu, tốt nhất nên đi khám bác sĩ để được tiến hành các xét nghiệm chẩn đoán bệnh như sau:
- Nhuộm soi cầu khuẩn lậu
- Nuôi cấy bệnh phẩm chứa cầu khuẩn lậu
- PCR cầu khuẩn lậu: Đây là phương pháp chẩn đoán xác định bệnh lậu đem lại kết quả chính xác trong thời gian ngắn nhất. Đồng thời phương pháp này có độ nhạy và độ đặc hiệu rất cao. Do đó có thể tiến hành xét nghiệm trên những bệnh nhân nghi ngờ nhiễm lậu dù chưa có biểu hiện bất kì triệu chứng nào rõ rệt.
- Xét nghiệm kháng thể IgG kháng Chlamydia giúp phát hiện bệnh nhiễm Chlamydia – một bệnh lây nhiễm qua đường tình dục đồng thời với vi khuẩn lậu và 1 số loại vi khuẩn khác.
Phương pháp điều trị bệnh lậu giai đoạn đầu hiệu quả
Đối với bệnh lậu giai đoạn đầu, phương pháp điều trị đơn giản nhất được bác sĩ chuyên khoa cân nhắc chỉ định là sử dụng thuốc kháng sinh. Đây là loại thuốc sẽ có công dụng ức chế sự phát triển của song cầu khuẩn lậu, đồng thời hạn chế mức độ viêm nhiễm cho bệnh gây ra.

Trong đa số các trường hợp mắc bệnh lậu nội khoa, ngoài việc sử dụng thuốc kháng sinh dạng uống, bác sĩ còn cân nhắc chỉ định kết hợp kháng sinh tiêm bắp một liều duy nhất. Tuy nhiên, loại thuốc này chống chỉ định với phụ nữ đang mang thai, phụ nữ đang cho con bú.
Bệnh lậu giai đoạn đầu là tiền đề cho các giai đoạn sau khởi phát nếu không được xét nghiệm phát hiện từ sớm và có phương pháp điều trị bệnh phù hợp. Một khi bệnh tình chuyển sang giai đoạn nặng nề dễ gây ra biến chứng nguy hiểm ảnh hưởng đến sức khỏe tổng thể và khả năng sinh sản. Chính vì vậy, hãy chủ động hơn trong việc kiểm tra sức khỏe ngay từ giai đoạn nghi ngờ hay xuất hiện triệu chứng bất thường không rõ nguyên nhân.
Bài viết được tham khảo từ bác sĩ và các nguồn tư liệu đáng tin cậy trong và ngoài nước. Tuy nhiên, Docosan Team khuyến khích bệnh nhân hãy tìm và đặt lịch hẹn với bác sĩ có chuyên môn để điều trị.











